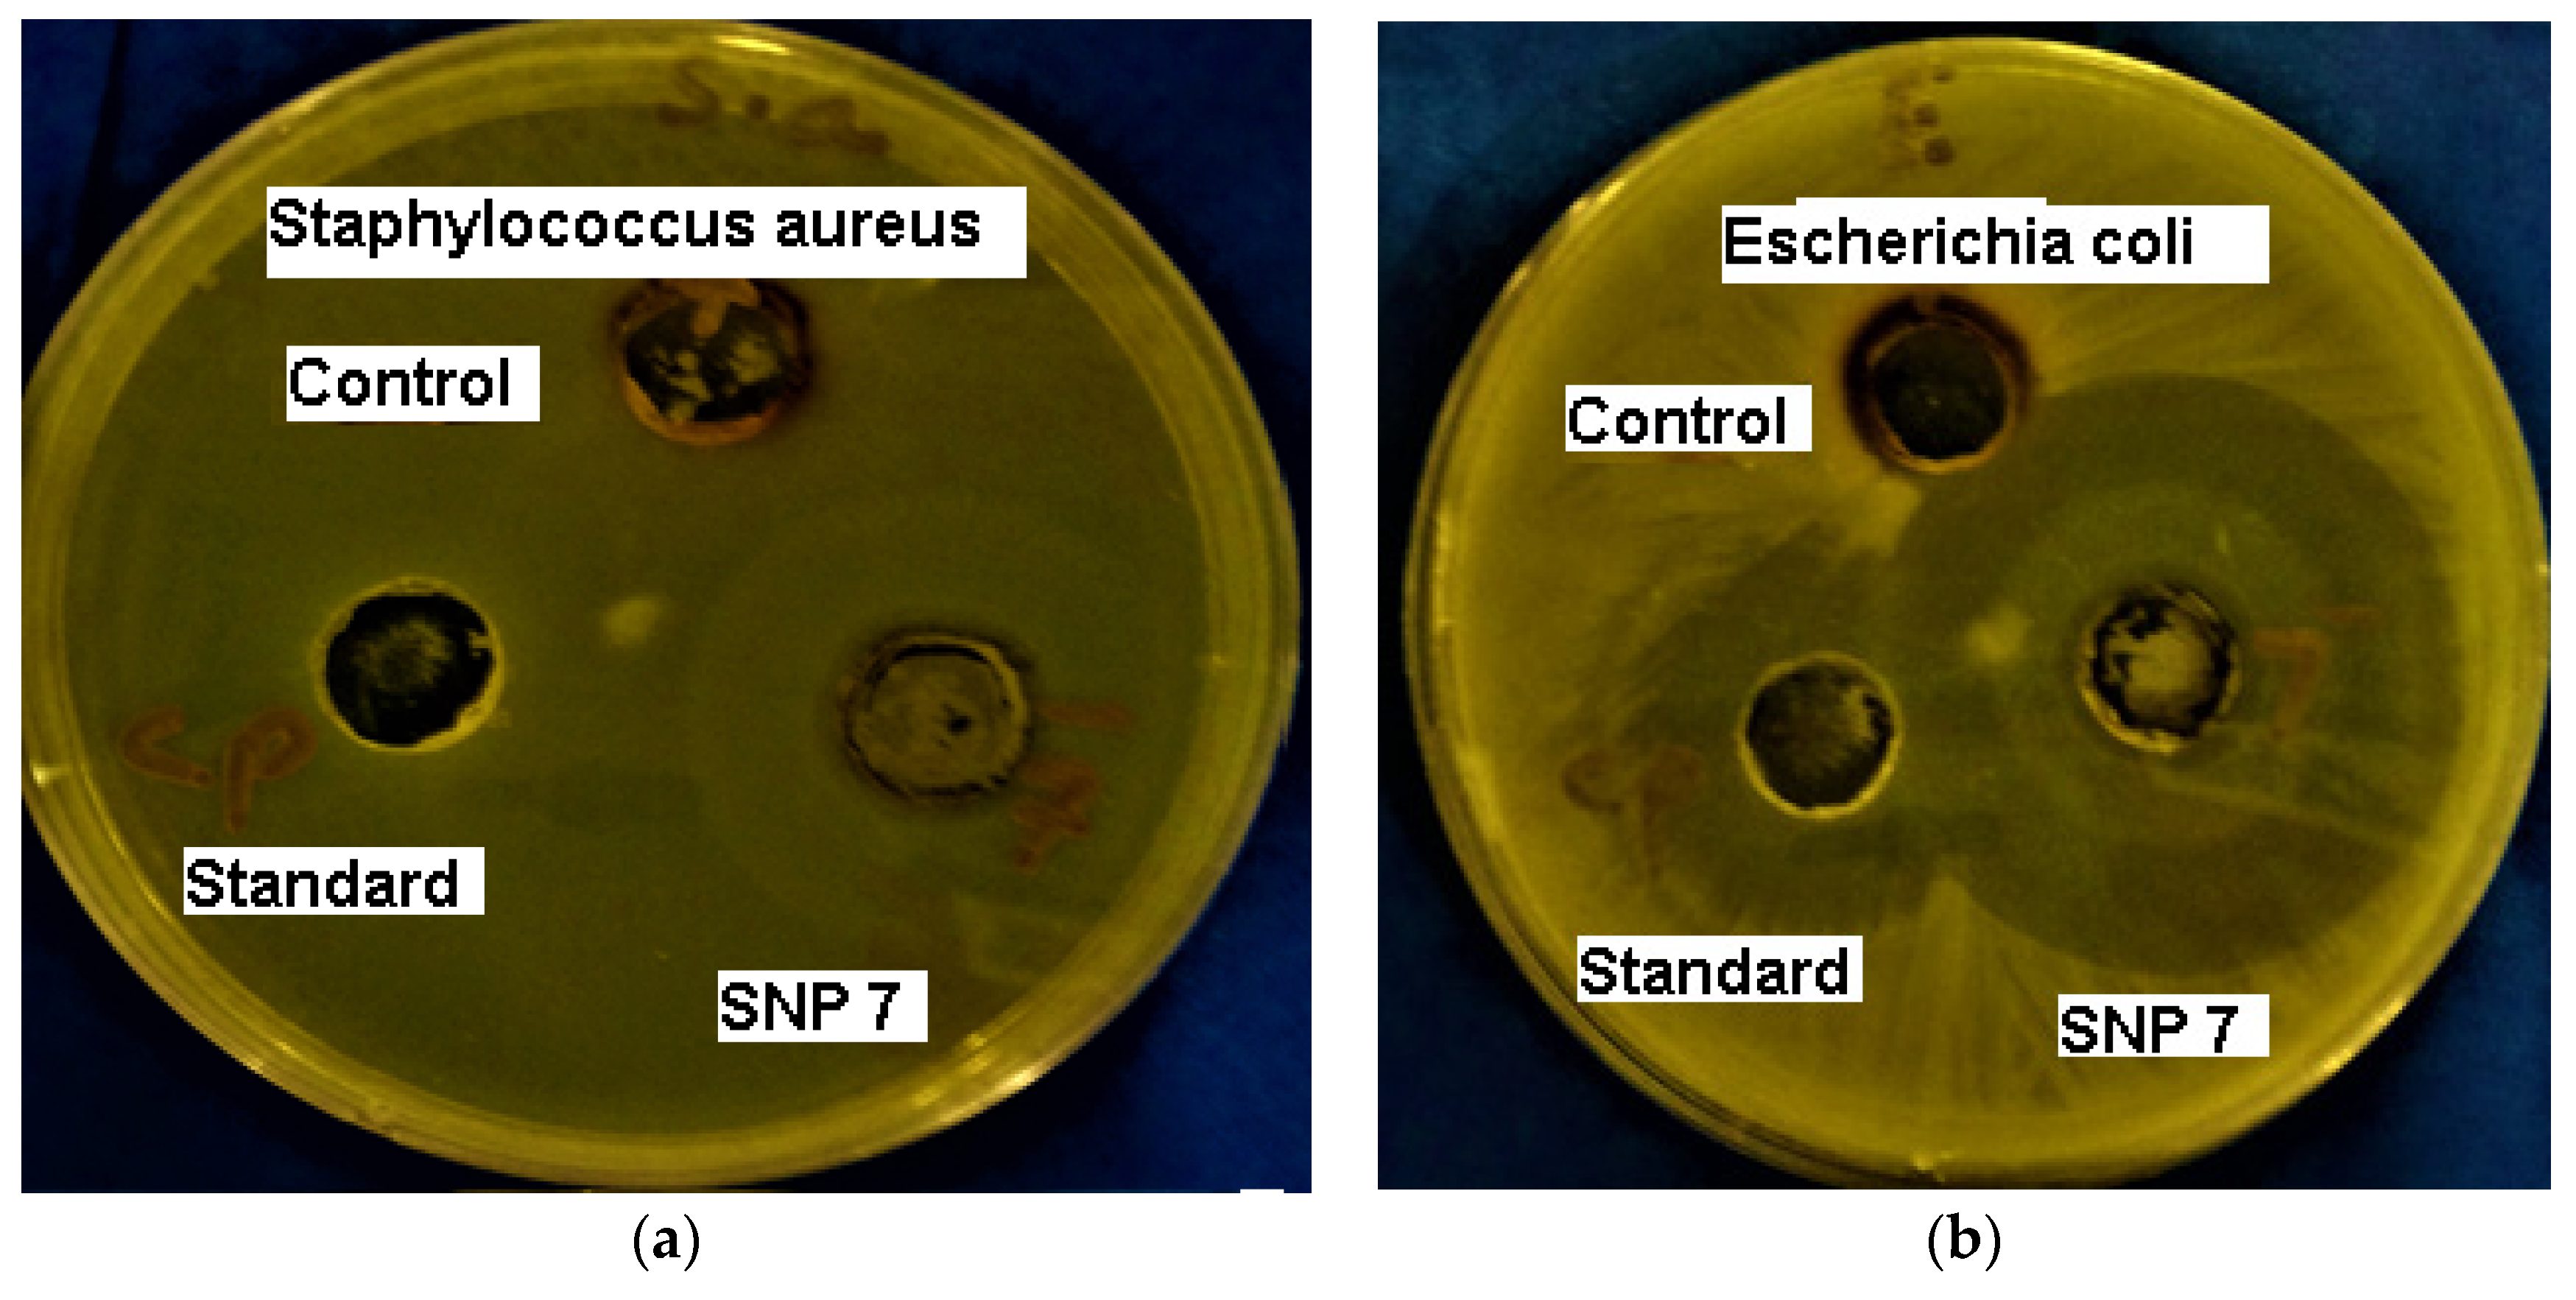
Coatings 12 01579 g014 Coatings 12 01579 g014

Gum Acacia- and Gum Tragacanth-Coated Silver Nanoparticles: Synthesis, Physiological Stability, In-Vitro, Ex-Vivo and In-Vivo Activity Evaluations
Abstract
1. Introduction
2. Materials and Methods
2.1. Synthesis and Characterization of SNPs
2.2. Effect of Physiological Buffers on the Prepration and Stability of SNPs
2.3. Effect of Sodium Hydroxide on the Prepration of SNPs
2.4. Effect of Silver Nitrate on the Prepration of SNPs
2.5. Effect of Dilution on SNPs
2.6. Stability of SNPs over a Time Period of 12 Months
2.7. Lyophilization of SNPs and Solid State Characterization
2.8. Antibacterial Activity Evaluation
2.9. Ex-Vivo and In-Vivo Activity Evaluation
2.9.1. Ex-Vivo Antispasmodic Activity Evaluation
2.9.2. In-Vivo Antidiarrheal Activity Evaluation
2.9.3. Statistical Analysis
3. Results
3.1. Synthesis and Characterization of SNPs
3.2. Effect of Physiological Buffers on the Prepration and Stability of SNPs
3.3. Effect of Sodium Hydroxide on the Prepration of SNPs
3.4. Effect of Silver Nitrate on the Prepration of SNPs
3.5. Effect of Dilution on SNPs
3.6. Stability of SNPs over a Time Period of 12 Months
3.7. Lyophilization of SNPs and Solid State Characterization
3.8. Antibacterial Activity Evaluation
3.9. Effect on Castor Oil-Induced Diarrhea
3.10. Effect on Isolated Rat Ileum
4. Discussion
4.1. Synthesis and Characterization of SNPs
4.2. Effect of Physiological Buffers on the Prepration and Stability of SNPs
4.3. Effect of Sodium Hydroxide on the Prepration of SNPs
4.4. Effect of Silver Nitrate on the Prepration of SNPs
4.5. Effect of Dilution on SNPs
4.6. Stability of SNPs over a Time Period of 12 Months
4.7. Solid State Characterization os SNPs
4.8. Antibacterial Activity Evaluation
4.9. Ex-Vivo and In-Vivo Activity Evaluation
5. Conclusions
Author Contributions
Funding
Institutional Review Board Statement
Informed Consent Statement
Data Availability Statement
Conflicts of Interest
References
- Guzman, M.; Dille, J.; Godet, S. Synthesis and antibacterial activity of silver nanoparticles against gram-positive and gram-negative bacteria. Nanomed. Nanotechnol. Biol. Med. 2012, 8, 37–45. [Google Scholar] [CrossRef] [PubMed]
- Iravani, S.; Korbekandi, H.; Mirmohammadi, S.V.; Zolfaghari, B. Synthesis of silver nanoparticles, chemical.; physical and biological methods. Res. Pharm. Sci. 2014, 9, 385–393. Available online: https://www.ncbi.nlm.nih.gov/pmc/articles/PMC4326978/ (accessed on 19 September 2022). [PubMed]
- Tran, Q.H.; Le, A.T. Silver nanoparticles, synthesis.; properties.; toxicology.; applications and perspectives. Adv. Nat. Sci. Nanosci. Nanotechnol. 2013, 4, 33001. [Google Scholar] [CrossRef]
- Almatroudi, A. Silver nanoparticles, Synthesis.; characterisation and biomedical applications. Open Life Sci. 2020, 15, 819–839. [Google Scholar] [CrossRef] [PubMed]
- Quintero-Quiroz, C.; Acevedo, N.; Zapata-Giraldo, J.; Botero, L.E.; Quintero, J.; Zárate-Triviño, D.; Saldarriaga, J.; Pérez, V.Z. Optimization of silver nanoparticle synthesis by chemical reduction and evaluation of its antimicrobial and toxic activity. Biomater. Res. 2019, 23, 27. [Google Scholar] [CrossRef] [PubMed]
- Sharifi-Rad, M.; Pohl, P. Synthesis of biogenic silver nanoparticles (Agcl-NPs) using a pulicaria vulgaris gaertn. aerial part extract and their application as antibacterial, antifungal and antioxidant agents. Nanomaterials 2020, 10, 638. [Google Scholar] [CrossRef]
- Patra, C.R.; Mukherjee, S.; Kotcherlakota, R. Biosynthesized silver nanoparticles, a step forward for cancer theranostics? Nanomedicine 2014, 9, 1445–1448. [Google Scholar] [CrossRef] [PubMed]
- Naik, A.N.; Patra, S.; Sen, D.; Goswami, A. Evaluating the mechanism of nucleation and growth of silver nanoparticles in a polymer membrane under continuous precursor supply, tuning of multiple to single nucleation pathway. Phys. Chem. Chem. Phys. 2019, 21, 4193–4199. [Google Scholar] [CrossRef]
- Jeong, Y.; Lim, D.W.; Choi, J. Assessment of size-dependent antimicrobial and cytotoxic properties of silver nanoparticles. Adv. Mater. Sci. Eng. 2014, 2014, 763807. [Google Scholar] [CrossRef]
- Dai, L.; Nadeau, B.; An, X.; Cheng, D.; Long, Z.; Ni, Y. Silver nanoparticles-containing dual-function hydrogels based on a guar gum-sodium borohydride system. Sci. Rep. 2016, 6, 36497. [Google Scholar] [CrossRef]
- Raza, M.A.; Kanwal, Z.; Rauf, A.; Sabri, A.N.; Riaz, S.; Naseem, S. Size-and shape-dependent antibacterial studies of silver nanoparticles synthesized by wet chemical routes. Nanomaterials 2016, 6, 74–79. [Google Scholar] [CrossRef] [PubMed]
- Li, H.; Xia, H.; Ding, W.; Li, Y.; Shi, Q.; Wang, D.; Tao, X. Synthesis of monodisperse.; quasi-spherical silver nanoparticles with sizes defined by the nature of silver precursors. Langmuir 2014, 30, 2498–2504. [Google Scholar] [CrossRef] [PubMed]
- Shahzad, A.; Chung, M.; Yu, T.; Kim, W.S. A Simple and Fast Aqueous--Phase Synthesis of Ultra--Highly Concentrated Silver Nanoparticles and Their Catalytic Properties. Chem. Asian J. 2015, 10, 2512–2517. [Google Scholar] [CrossRef]
- Mlalila, N.; Swai, H.; Hilonga, A. Optimized Preparation of Silver Nanoparticles from Polyethylene Glycol and Formaldehyde. Int. Res. J. Pure Appl. Chem. 2016, 13, 1–9. [Google Scholar] [CrossRef]
- Nishioka, M.; Miyakawa, M.; Kataoka, H.; Koda, H.; Sato, K.; Suzuki, T.M. Continuous synthesis of monodispersed silver nanoparticles using a homogeneous heating microwave reactor system. Nanoscale 2011, 3, 2621–2626. [Google Scholar] [CrossRef]
- Bortoli, L.D.; Palácio, S.M.; Hermes, E.; Zenatti, D.C.; Veit, M.T.; Campos, É.A. Removal of silver nanoparticles coated with different stabilizers from aqueous medium by electrocoagulation. Environ. Technol. 2020, 41, 1139–1150. [Google Scholar] [CrossRef] [PubMed]
- Lanje, A.S.; Sharma, S.J.; Pode, R.B. Synthesis of silver nanoparticles, A safer alternative to conventional antimicrobial and antibacterial agents. J. Chem. Pharm. Res. 2010, 2, 478–483. [Google Scholar]
- Mehta, S.K.; Chaudhary, S.; Gradzielski, M. Time dependence of nucleation and growth of silver nanoparticles generated by sugar reduction in micellar media. J. Colloid Interface Sci. 2010, 343, 447–453. [Google Scholar] [CrossRef]
- Oluwafemi, O.S.; Lucwaba, Y.; Gura, A.; Masabeya, M.; Ncapayi, V.; Olujimi, O.O.; Songca, S.P. A facile completely ‘green’size tunable synthesis of maltose-reduced silver nanoparticles without the use of any accelerator. Colloids Surf. B. Biointerfaces 2013, 102, 718–723. [Google Scholar] [CrossRef]
- Meshram, S.M.; Bonde, S.R.; Gupta, I.R.; Gade, A.K.; Rai, M.K. Green synthesis of silver nanoparticles using white sugar. IET Nanobiotechnol. 2013, 7, 28–32. [Google Scholar] [CrossRef]
- Suwan, T.; Khongkhunthian, S.; Okonogi, S. Silver nanoparticles fabricated by reducing property of cellulose derivatives. Drug Discov. Ther. 2019, 13, 70–79. [Google Scholar] [CrossRef] [PubMed]
- Wang, L.S.; Wang, C.Y.; Yang, C.H.; Hsieh, C.L.; Chen, S.Y.; Shen, C.Y.; Wang, J.J.; Huang, K.S. Synthesis and anti-fungal effect of silver nanoparticles-chitosan composite particles. Int. J. Nanomed. 2015, 10, 2685–2696. [Google Scholar] [CrossRef]
- Cortes, Y.Z.; Valenzuela, L.M.; Pena, E.A.E.; Sanchez, B.L.E. Antibacterial Activity of Electrospun Nanocomposites Fabricated by in Situ Chitosan/Silver Nanoparticles. IEEE Trans. Nanobiosci. 2022, 21, 89–96. [Google Scholar] [CrossRef] [PubMed]
- Baláž, M.; Bedlovičová, Z.; Daneu, N.; Siksa, P.; Sokoli, L.; Tkáčiková, Ľ.; Salayová, A.; Džunda, R.; Kováčová, M.; Bureš, R.; et al. Mechanochemistry as an Alternative Method of Green Synthesis of Silver Nanoparticles with Antibacterial Activity, A Comparative Study. Nanomaterials 2021, 11, 1139. [Google Scholar] [CrossRef] [PubMed]
- Mohan, S.; Oluwafemi, O.S.; George, S.C.; Jayachandran, V.P.; Lewu, F.B.; Songca, S.P.; Kalarikkal, N.; Thomas, S. Completely green synthesis of dextrose reduced silver nanoparticles, its antimicrobial and sensing properties. Carbohydr. Polym. 2014, 106, 469–474. [Google Scholar] [CrossRef] [PubMed]
- Bruniera, J.F.B.; Gabriel-Silva, L.; Goulart, R.S.; Silva-Sousa, Y.T.C.; Lara, M.G.; Pitondo-Silva, A.; Miranda, C.E.S. Green Synthesis, Characterization and Antimicrobial Evaluation of Silver Nanoparticles for an Intracanal Dressing. Braz. Dent. J. 2020, 31, 485–492. [Google Scholar] [CrossRef]
- White, R.J.; Budarin, V.L.; Moir, J.W.; Clark, J.H. A sweet killer, mesoporous polysaccharide confined silver nanoparticles for antibacterial applications. Int. J. Mol. Sci. 2011, 12, 5782–5796. [Google Scholar] [CrossRef]
- El-Rafie, M.H.; Ahmed, H.B.; Zahran, M.K. Facile Precursor for Synthesis of Silver Nanoparticles Using Alkali Treated Maize Starch. Int. Sch. Res. Not. 2014, 2014, 702396. [Google Scholar] [CrossRef] [PubMed]
- Alzahrani, E. Colorimetric Detection Based on Localised Surface Plasmon Resonance Optical Characteristics for the Detection of Hydrogen Peroxide Using Acacia Gum-Stabilised Silver Nanoparticles. Anal. Chem. Insights 2017, 12, 1177390116684686. [Google Scholar] [CrossRef]
- Kora, A.J.; Arunachalam, J. Green fabrication of silver nanoparticles by gum tragacanth (Astragalus gummifer), a dual functional reductant and stabilizer. J. Nanomater. 2012, 2012, 869765. [Google Scholar] [CrossRef]
- Iqbal, D.N.; Shafiq, S.; Khan, S.M.; Ibrahim, S.M.; Abubshait, S.A.; Nazir, A.; Abbas, M.; Iqbal, M. Novel chitosan/guar gum/PVA hydrogel, Preparation.; characterization and antimicrobial activity evaluation. Int. J. Biol. Macromol. 2020, 164, 499–509. [Google Scholar] [CrossRef] [PubMed]
- Deka, R.; Sarma, S.; Patar, P.; Gogoi, P.; Sarmah, J.K. Highly stable silver nanoparticles containing guar gum modified dual network hydrogel for catalytic and biomedical applications. Carbohydr. Polym. 2020, 248, 116786. [Google Scholar] [CrossRef]
- Zulkifli, N.I.; Muhamad, M.; Zain, N.N.M.; Tan, W.N.; Yahaya, N.; Bustami, Y.; Abdul Aziz, A.; Kamal, N.N.S. A Bottom-Up Synthesis Approach to Silver Nanoparticles Induces Anti-Proliferative and Apoptotic Activities Against MCF-7.; MCF-7/TAMR-1 and MCF-10A Human Breast Cell Lines. Molecules 2020, 25, 4332. [Google Scholar] [CrossRef]
- Jalab, J.; Abdelwahed, W.; Kitaz, A.; Al-Kayali, R. Green synthesis of silver nanoparticles using aqueous extract of Acacia cyanophylla and its antibacterial activity. Heliyon 2021, 7, e08033. [Google Scholar] [CrossRef]
- Mechouche, M.S.; Merouane, F.; Messaad, C.E.H.; Golzadeh, N.; Vasseghian, Y.; Berkani, M. Biosynthesis.; characterization.; and evaluation of antibacterial and photocatalytic methylene blue dye degradation activities of silver nanoparticles from Streptomyces tuirus strain. Environ. Res. 2022, 204 Pt D, 112360. [Google Scholar] [CrossRef] [PubMed]
- Simon, S.; Sibuyi, N.R.S.; Fadaka, A.O.; Meyer, M.; Madiehe, A.M.; du Preez, M.G. The antimicrobial activity of biogenic silver nanoparticles synthesized from extracts of Red and Green European pear cultivars. Artif. Cells Nanomed. Biotechnol. 2021, 49, 614–625. [Google Scholar] [CrossRef]
- Bonev, B.; Hooper, J.; Parisot, J. Principles of assessing bacterial susceptibility to antibiotics using the agar diffusion method. J. Antimicrob. Chemother. 2008, 61, 1295–1301. [Google Scholar] [CrossRef]
- Ansari, M.J.; Althubaiti, M.; Ibnouf, M.O.; Anwer, M.K.; Ahmed, M.M.; Fatima, F.; Jamil, S. Enhanced Antibacterial Effects of Ciprofloxacin Enclosed In Cyclodextrin and Nano-Suspension Carrier Systems. Bull. Env. Pharmacol. Life Sci. 2015, 4, 14–18. [Google Scholar]
- Farre, A.J.; Columbo, M.; Fort, M.; Gutierrez, B. Differential effects of various Ca++ antagonists. Gen. Pharmacol. 1991, 22, 177–181. [Google Scholar] [CrossRef]
- National Research Council. Guide for the Care and Use of Laboratory Animals; National Academy Press: Washington, DC, USA, 1996; pp. 1–7. Available online: https://www.ncbi.nlm.nih.gov/books/NBK54050/ (accessed on 10 March 2022).
- Rehman, N.U.; Khan, A.; Fatima, U.; Akram, M.; Al-Musayeib, N.; Al-Massarani, S.; El-Gamal, A.; Gilani, A.H. Presence of laxative and antidiarrheal activities in Periploca aphylla, a Saudi medicinal plant. Int. J. Pharmacol. 2013, 9, 190–196. [Google Scholar] [CrossRef]
- Tischer, C.A.; Iacomini, M.; Gorin, P.A. Structure of the arabinogalactan from gum tragacanth (Astralagus gummifer). Carbohydr. Res. 2002, 337, 1647–1655. [Google Scholar] [CrossRef]
- Nejatian, M.; Abbasi, S.; Azarikia, F. Gum Tragacanth, Structure.; characteristics and applications in foods. Int. J. Biol. Macromol. 2020, 160, 846–860. [Google Scholar] [CrossRef] [PubMed]
- Desai, R.; Mankad, V.; Gupta, S.K.; Jha, P.K. Size distribution of silver nanoparticles, UV-visible spectroscopic assessment. Nanosci. Nanotechnol. Lett. 2012, 4, 30–34. [Google Scholar] [CrossRef]
- Sharma, G.; Nam, J.S.; Sharma, A.R.; Lee, S.S. Antimicrobial potential of silver nanoparticles synthesized using medicinal herb coptidis rhizome. Molecules 2018, 23, 2268. [Google Scholar] [CrossRef]
- De Leersnyder, I.; De Gelder, L.; Van Driessche, I.; Vermeir, P. Revealing the importance of aging.; environment.; size and stabilization mechanisms on the stability of metal nanoparticles, A case study for silver nanoparticles in a minimally defined and complex undefined bacterial growth medium. Nanomaterials 2019, 9, 1684. [Google Scholar] [CrossRef] [PubMed]
- Indana, M.K.; Gangapuram, B.R.; Dadigala, R.; Bandi, R.; Guttena, V. A novel green synthesis and characterization of silver nanoparticles using gum tragacanth and evaluation of their potential catalytic reduction activities with methylene blue and Congo red dyes. J. Anal. Sci. Technol. 2016, 7, 19. [Google Scholar] [CrossRef]
- Venkatesham, M.; Ayodhya, D.; Madhusudhan, A.; Veera Babu, N.; Veerabhadram, G. A novel green one-step synthesis of silver nanoparticles using chitosan, catalytic activity and antimicrobial studies. Appl. Nanosci. 2014, 4, 113–119. [Google Scholar] [CrossRef]
- Dong, C.; Zhang, X.; Cai, H. Green synthesis of monodisperse silver nanoparticles using hydroxy propyl methyl cellulose. J. Alloys Compd. 2014, 583, 267–271. [Google Scholar] [CrossRef]
- Nishimura, S.; Mott, D.; Takagaki, A.; Maenosono, S.; Ebitani, K. Role of base in the formation of silver nanoparticles synthesized using sodium acrylate as a dual reducing and encapsulating agent. Phys. Chem. Chem. Phys. 2011, 13, 9335–9343. [Google Scholar] [CrossRef] [PubMed]
- Yadav, V.D.; Jain, R.; Dandekar, P. Influence of sodium hydroxide in enhancing the surface plasmon resonance of silver nanoparticles. Mater. Res. Express 2017, 4, 085015. [Google Scholar] [CrossRef]
- Singh, M.; Sinha, I.; Mandal, R.K. Role of pH in the green synthesis of silver nanoparticles. Mater. Lett. 2009, 63, 425–427. [Google Scholar] [CrossRef]
- Sobczak-Kupiec, A.; Malina, D.; Wzorek, Z.; Zimowska, M. Influence of silver nitrate concentration on the properties of silver nanoparticles. Micro Nano Lett. 2011, 6, 656–660. [Google Scholar] [CrossRef]
- Htwe, Y.Z.; Chow, W.S.; Suda, Y.; Mariatti, M. Effect of silver nitrate concentration on the production of silver nanoparticles by green method. Mater. Today Proc. 2019, 7, 568–573. [Google Scholar] [CrossRef]
- Chhatre, A.; Solasa, P.; Sakle, S.; Thaokar, R.; Mehra, A. Color and surface plasmon effects in nanoparticle systems: Case of silver nanoparticles prepared by microemulsion route. Colloids Surf. A Physicochem. Eng. Asp. 2012, 404, 83–92. [Google Scholar] [CrossRef]
- El-Sheikh, M.A.; El-Rafie, S.M.; Abdel-Halim, E.S.; El-Rafie, M.H. Green synthesis of hydroxyethyl cellulose-stabilized silver nanoparticles. J. Polym. 2013, 2013, 650837. [Google Scholar] [CrossRef]
- Sharma, R.; Dhillon, A.; Kumar, D. Mentha-stabilized silver nanoparticles for high-performance colorimetric detection of Al (III) in aqueous systems. Sci. Rep. 2018, 8, 5189. [Google Scholar] [CrossRef]
- Rajendrachari, S.; Kumaraswamy, B.E. Biosynthesis of silver nanoparticles using leaves of Acacia melanoxylon and their application as dopamine and hydrogen peroxide sensors. Phys. Chem. Res. 2020, 8, 1–18. [Google Scholar]
- Kumar, K.P.; Paul, W.; Sharma, C.P. Green synthesis of silver nanoparticles with Zingiber officinale extract and study of its blood compatibility. Bionanoscience 2012, 2, 144–152. [Google Scholar] [CrossRef]
- Kent, R.D.; Vikesland, P.J. Controlled evaluation of silver nanoparticle dissolution using atomic force microscopy. Environ. Sci. Technol. 2012, 46, 6977–6984. [Google Scholar] [CrossRef]
- Sharma, V.K.; Siskova, K.M.; Zboril, R.; Gardea-Torresdey, J.L. Organic-coated silver nanoparticles in biological and environmental conditions: Fate, stability and toxicity. Adv. Colloid Interface Sci. 2014, 204, 15–34. [Google Scholar] [CrossRef]
- González, A.L.; Noguez, C.; Beránek, J.; Barnard, A.S. Size, shape, stability, and color of plasmonic silver nanoparticles. J. Phys. Chem. C 2014, 118, 9128–9136. [Google Scholar] [CrossRef]
- Gilani, A.H.; Shaheen, F.; Christopoulos, A.; Mitchelson, F. Interaction of ebeinone, an alkaloid from Fritillaria imperialis, at two muscarinic acetylcholine receptor subtypes. Life Sci. 1997, 60, 535–544. [Google Scholar] [CrossRef]
- Fleckenstein, A. Specific pharmacology of Ca++ in myocardium.; cardiac pacemakers and vascular smooth muscle. Rev. Pharmacol. Toxicol. 1977, 17, 149–166. [Google Scholar] [CrossRef] [PubMed]
- Rehman, N.U.; Ansari, M.N.; Ahmad, W.; Ahamad, S.R. Dual inhibition of phosphodiesterase and Ca++ channels explain the medicinal use of Balanites aegyptiaca (L.) in hyperactive gut disorders. Plants 2022, 11, 1183. [Google Scholar] [CrossRef]
- Wintola, O.A.; Sunmonu, T.O.; Afolayan, A.J. The effect of Aloe ferox Mill. in the treatment of loperamide-induced constipation in Wistar rats. BMC Gastroenterol. 2010, 10, 95. [Google Scholar] [CrossRef]
- Croci, T.; Landi, M.; Elmonds-Alt, X.; Le Fur, G.; Maffrand, J.P.; Manara, L. Role of tachykinins in castor oil induced diarrhea in rats. Br. J. Pharmacol. 1997, 121, 375–380. [Google Scholar] [CrossRef] [PubMed]
- Downie, J.W.; Twiddy, D.A.; Awad, S.A. Antimuscarinic and non-competitive antagonist properties of dicyclomine hydrochloride in isolated human and rabbit bladder muscle. J. Pharmacol. Exp. Ther. 1977, 201, 662–668. [Google Scholar]
- Pasricha, P.J. Treatment of disorders of bowel motility and water flux; antiemetics; agents used in bilary and pancreatic diseases. In The Pharmacological Basis of Therapeutics, 11th ed.; McGraw-Hill: New York, NY, USA, 2006; pp. 983–1008. [Google Scholar]

| Diluents | 0 Min | 15 Min | 30 Min | 45 Min | 60 Min | 120 Min | Mean Size (nm) ± SD | Mean PDI ± SD | ||||||
|---|---|---|---|---|---|---|---|---|---|---|---|---|---|---|
| Size | PDI | Size | PDI | Size | PDI | Size | PDI | Size | PDI | Size | PDI | |||
| DW | 130.1 | 0.158 | 134.5 | 0.149 | 142.7 | 0.037 | 143.2 | 0.064 | 140 | 0.106 | 133.6 | 0.198 | 137.4 ± 5.4 | 0.119 ± 0.061 |
| SGF | 149.8 | 0.033 | 169.7 | 0.124 | 186.7 | 0.133 | 199.6 | 0.151 | 204.7 | 0.176 | 226.5 | 0.137 | 189.5 ± 27.1 | 0.126 ± 0.049 |
| AB | 141.6 | 0.213 | 152.7 | 0.164 | 174.5 | 0.142 | 164.4 | 0.161 | 162.5 | 0.196 | 170.2 | 0.168 | 161.0 ± 12.0 | 0.174 ± 0.026 |
| SIF | 154.9 | 0.232 | 136.6 | 0.25 | 143.8 | 0.234 | 142.2 | 0.231 | 156 | 0.031 | 147.1 | 0.201 | 146.8 ± 7.5 | 0.197 ± 0.083 |
| PBS | 100.4 | 0.187 | 121.4 | 0.165 | 129.6 | 0.178 | 133.9 | 0.177 | 144.2 | 0.092 | 144.2 | 0.167 | 129.0 ± 16.5 | 0.161 ± 0.035 |
| Zone of Inhibition (mm) | |||
|---|---|---|---|
| Strains | Sample | Ciprofloxacin | Silver Nanoparticles |
| S. aureus | 1 | 18.0 | 35.0 |
| ATCC # | 2 | 19.0 | 33.0 |
| 25923 | 3 | 18.0 | 36.0 |
| - | MEAN | 18.3 | * 34.7 |
| - | SD | 0.6 | 1.5 |
| E. coli | 1 | 30.0 | 45.0 |
| ATCC # | 2 | 28.0 | 44.0 |
| 13706 | 3 | 30.0 | 44.0 |
| - | MEAN | 29.3 | * 44.3 |
| - | SD | 1.2 | 0.6 |
| Groups | Dose (mg/kg) | No. of Wet Stool | Total No. of Stool |
|---|---|---|---|
| Saline | 10 mL/kg (p.o) | 5.2 ± 0.48 | 5.8 ± 1.3 |
| SNPs | 1 mg/kg (i.p) | 3.4 ± 0.24 * | 6.4 ± 2.07 ns |
| SNPs | 3 mg/kg (i.p) | 2.6 ± 0.50 ** | 7.2 ± 2.7 ns |
| SNPs | 10 mg/kg (i.p) | 2.0 ± 1.00 *** | 8.2 ± 4.3 ns |
| Loperamide | 10 mg/kg (i.p) | 0.60 ± 0.40 *** | 1 ± 1.41 ** |
Publisher’s Note: MDPI stays neutral with regard to jurisdictional claims in published maps and institutional affiliations. |
© 2022 by the authors. Licensee MDPI, Basel, Switzerland. This article is an open access article distributed under the terms and conditions of the Creative Commons Attribution (CC BY) license (https://creativecommons.org/licenses/by/4.0/).
Share and Cite
Ansari, M.J.; Rehman, N.U.; Ibnouf, E.; Alalaiwe, A.; Ganaie, M.A.; Zafar, A. Gum Acacia- and Gum Tragacanth-Coated Silver Nanoparticles: Synthesis, Physiological Stability, In-Vitro, Ex-Vivo and In-Vivo Activity Evaluations. Coatings 2022, 12, 1579. https://doi.org/10.3390/coatings12101579
Ansari MJ, Rehman NU, Ibnouf E, Alalaiwe A, Ganaie MA, Zafar A. Gum Acacia- and Gum Tragacanth-Coated Silver Nanoparticles: Synthesis, Physiological Stability, In-Vitro, Ex-Vivo and In-Vivo Activity Evaluations. Coatings. 2022; 12(10):1579. https://doi.org/10.3390/coatings12101579
Chicago/Turabian StyleAnsari, Mohammad Javed, Najeeb Ur Rehman, Elmoatasim Ibnouf, Ahmed Alalaiwe, Majid Ahmad Ganaie, and Ameeduzzafar Zafar. 2022. "Gum Acacia- and Gum Tragacanth-Coated Silver Nanoparticles: Synthesis, Physiological Stability, In-Vitro, Ex-Vivo and In-Vivo Activity Evaluations" Coatings 12, no. 10: 1579. https://doi.org/10.3390/coatings12101579
APA StyleAnsari, M. J., Rehman, N. U., Ibnouf, E., Alalaiwe, A., Ganaie, M. A., & Zafar, A. (2022). Gum Acacia- and Gum Tragacanth-Coated Silver Nanoparticles: Synthesis, Physiological Stability, In-Vitro, Ex-Vivo and In-Vivo Activity Evaluations. Coatings, 12(10), 1579. https://doi.org/10.3390/coatings12101579

